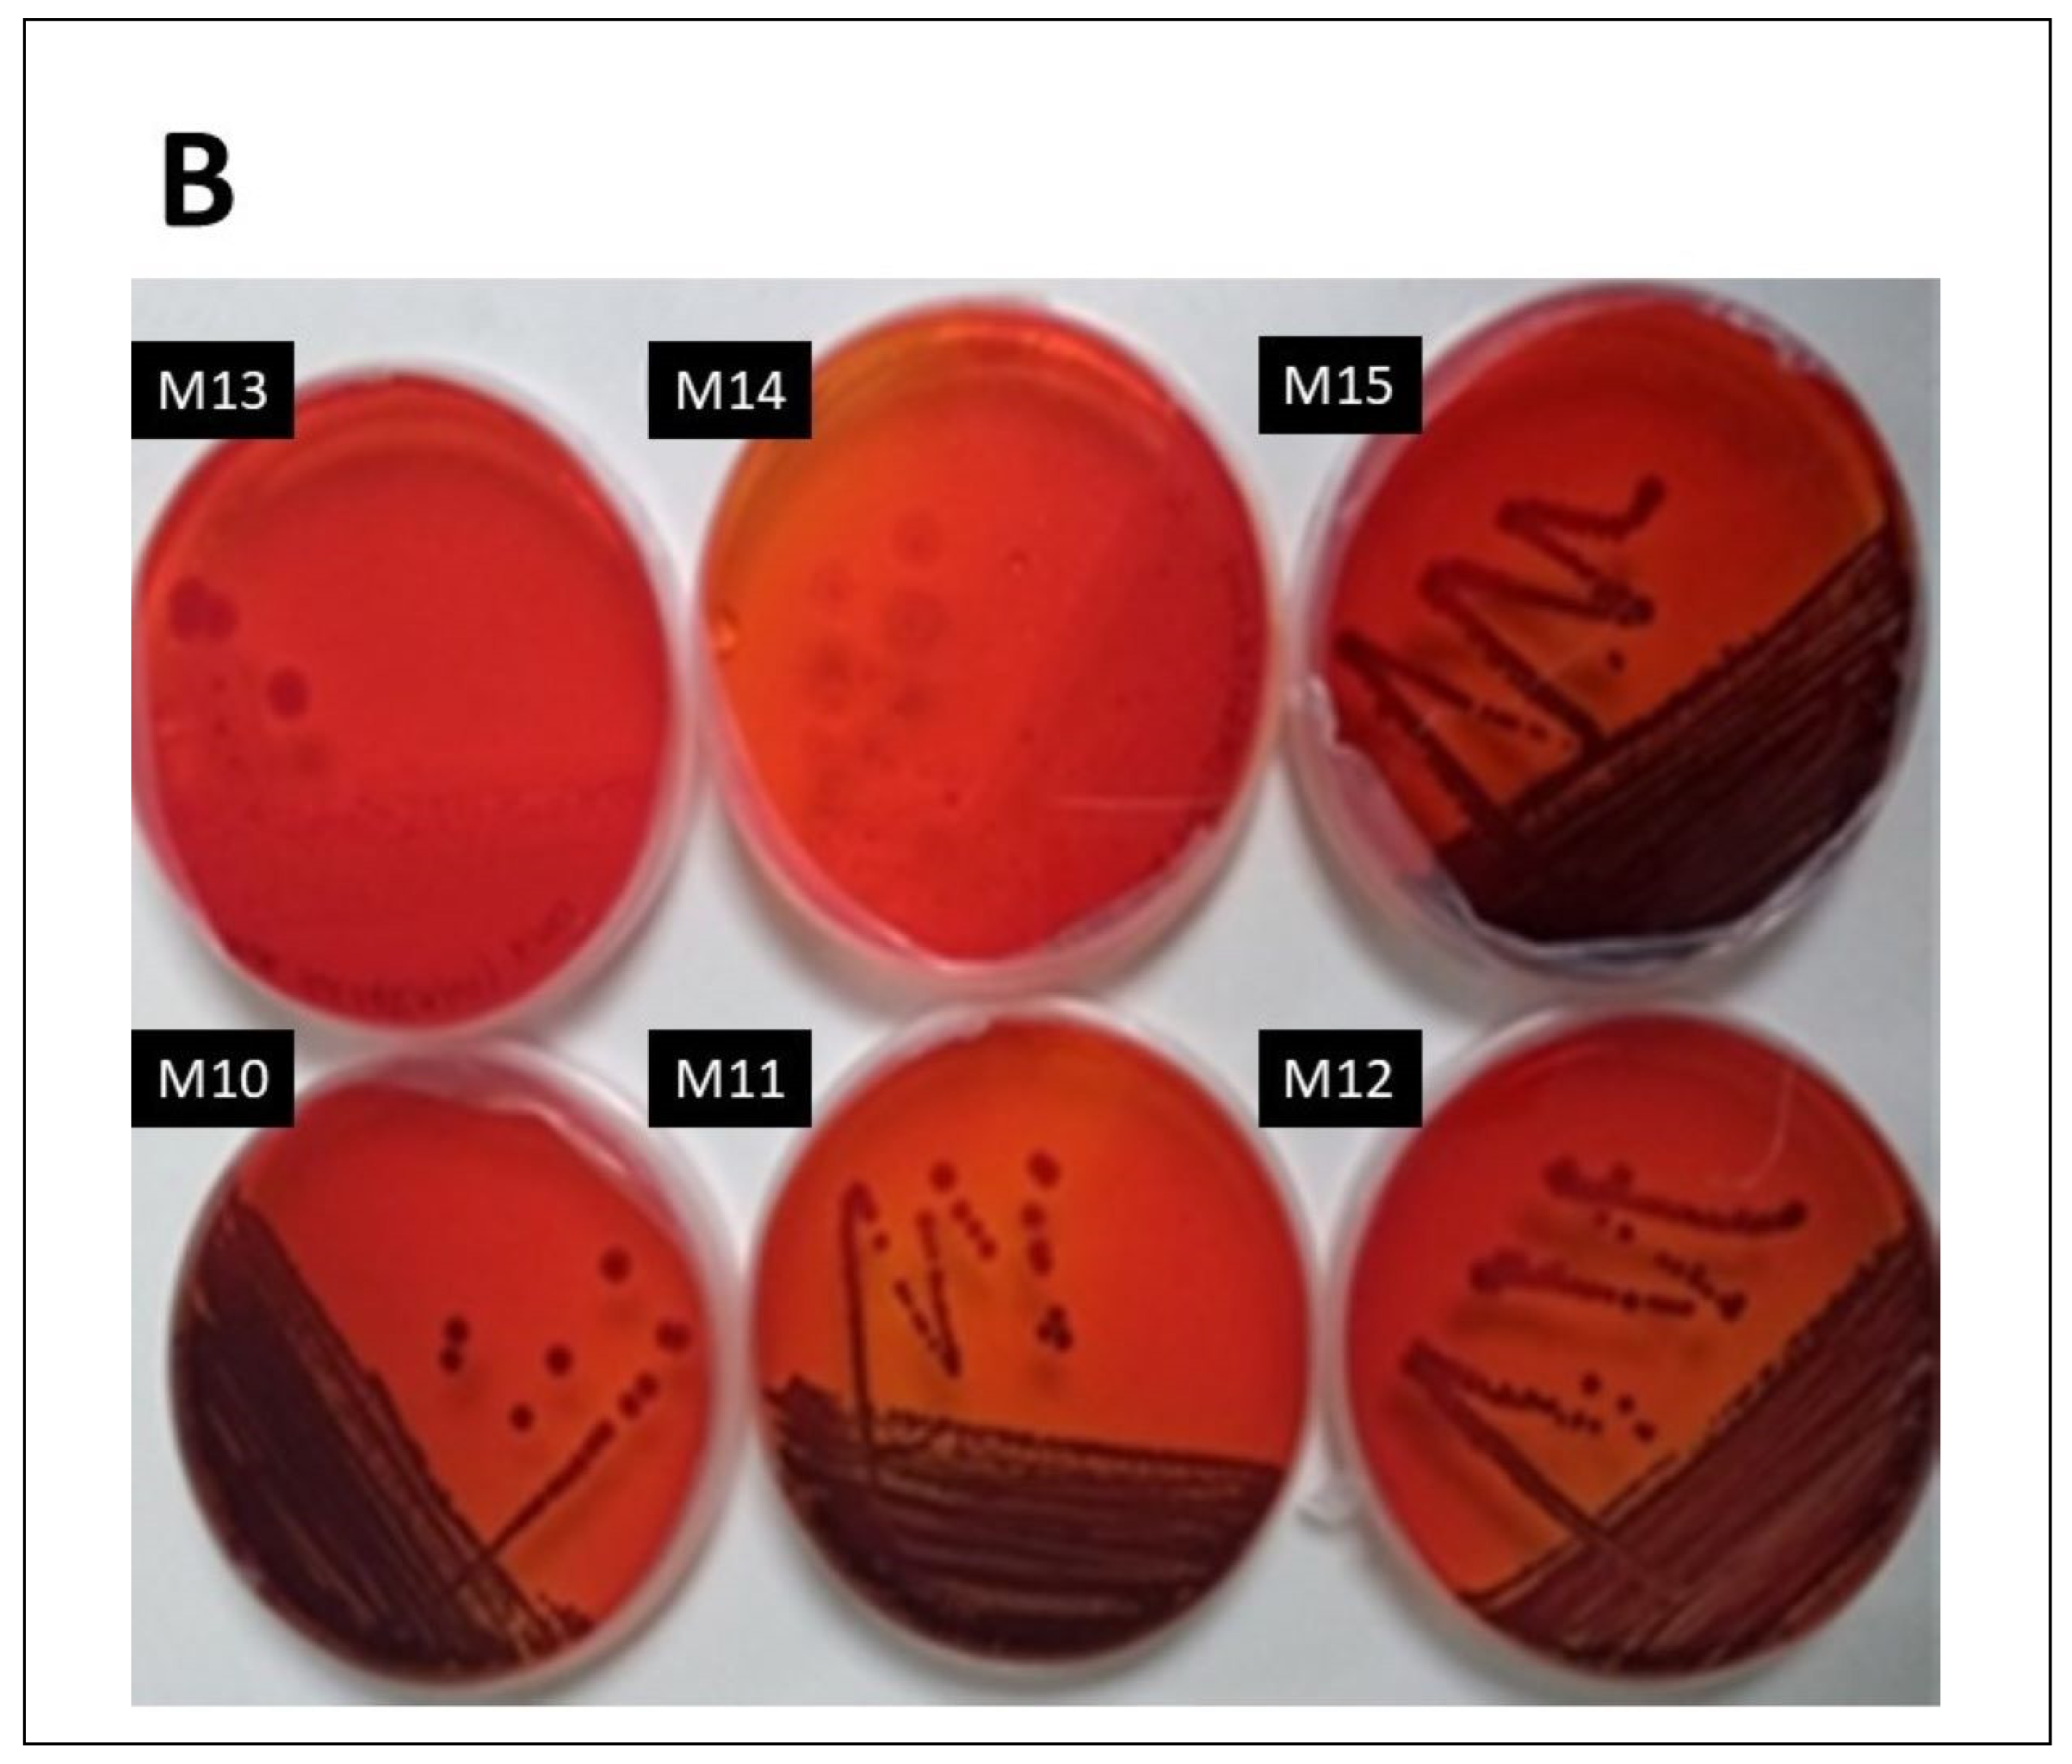
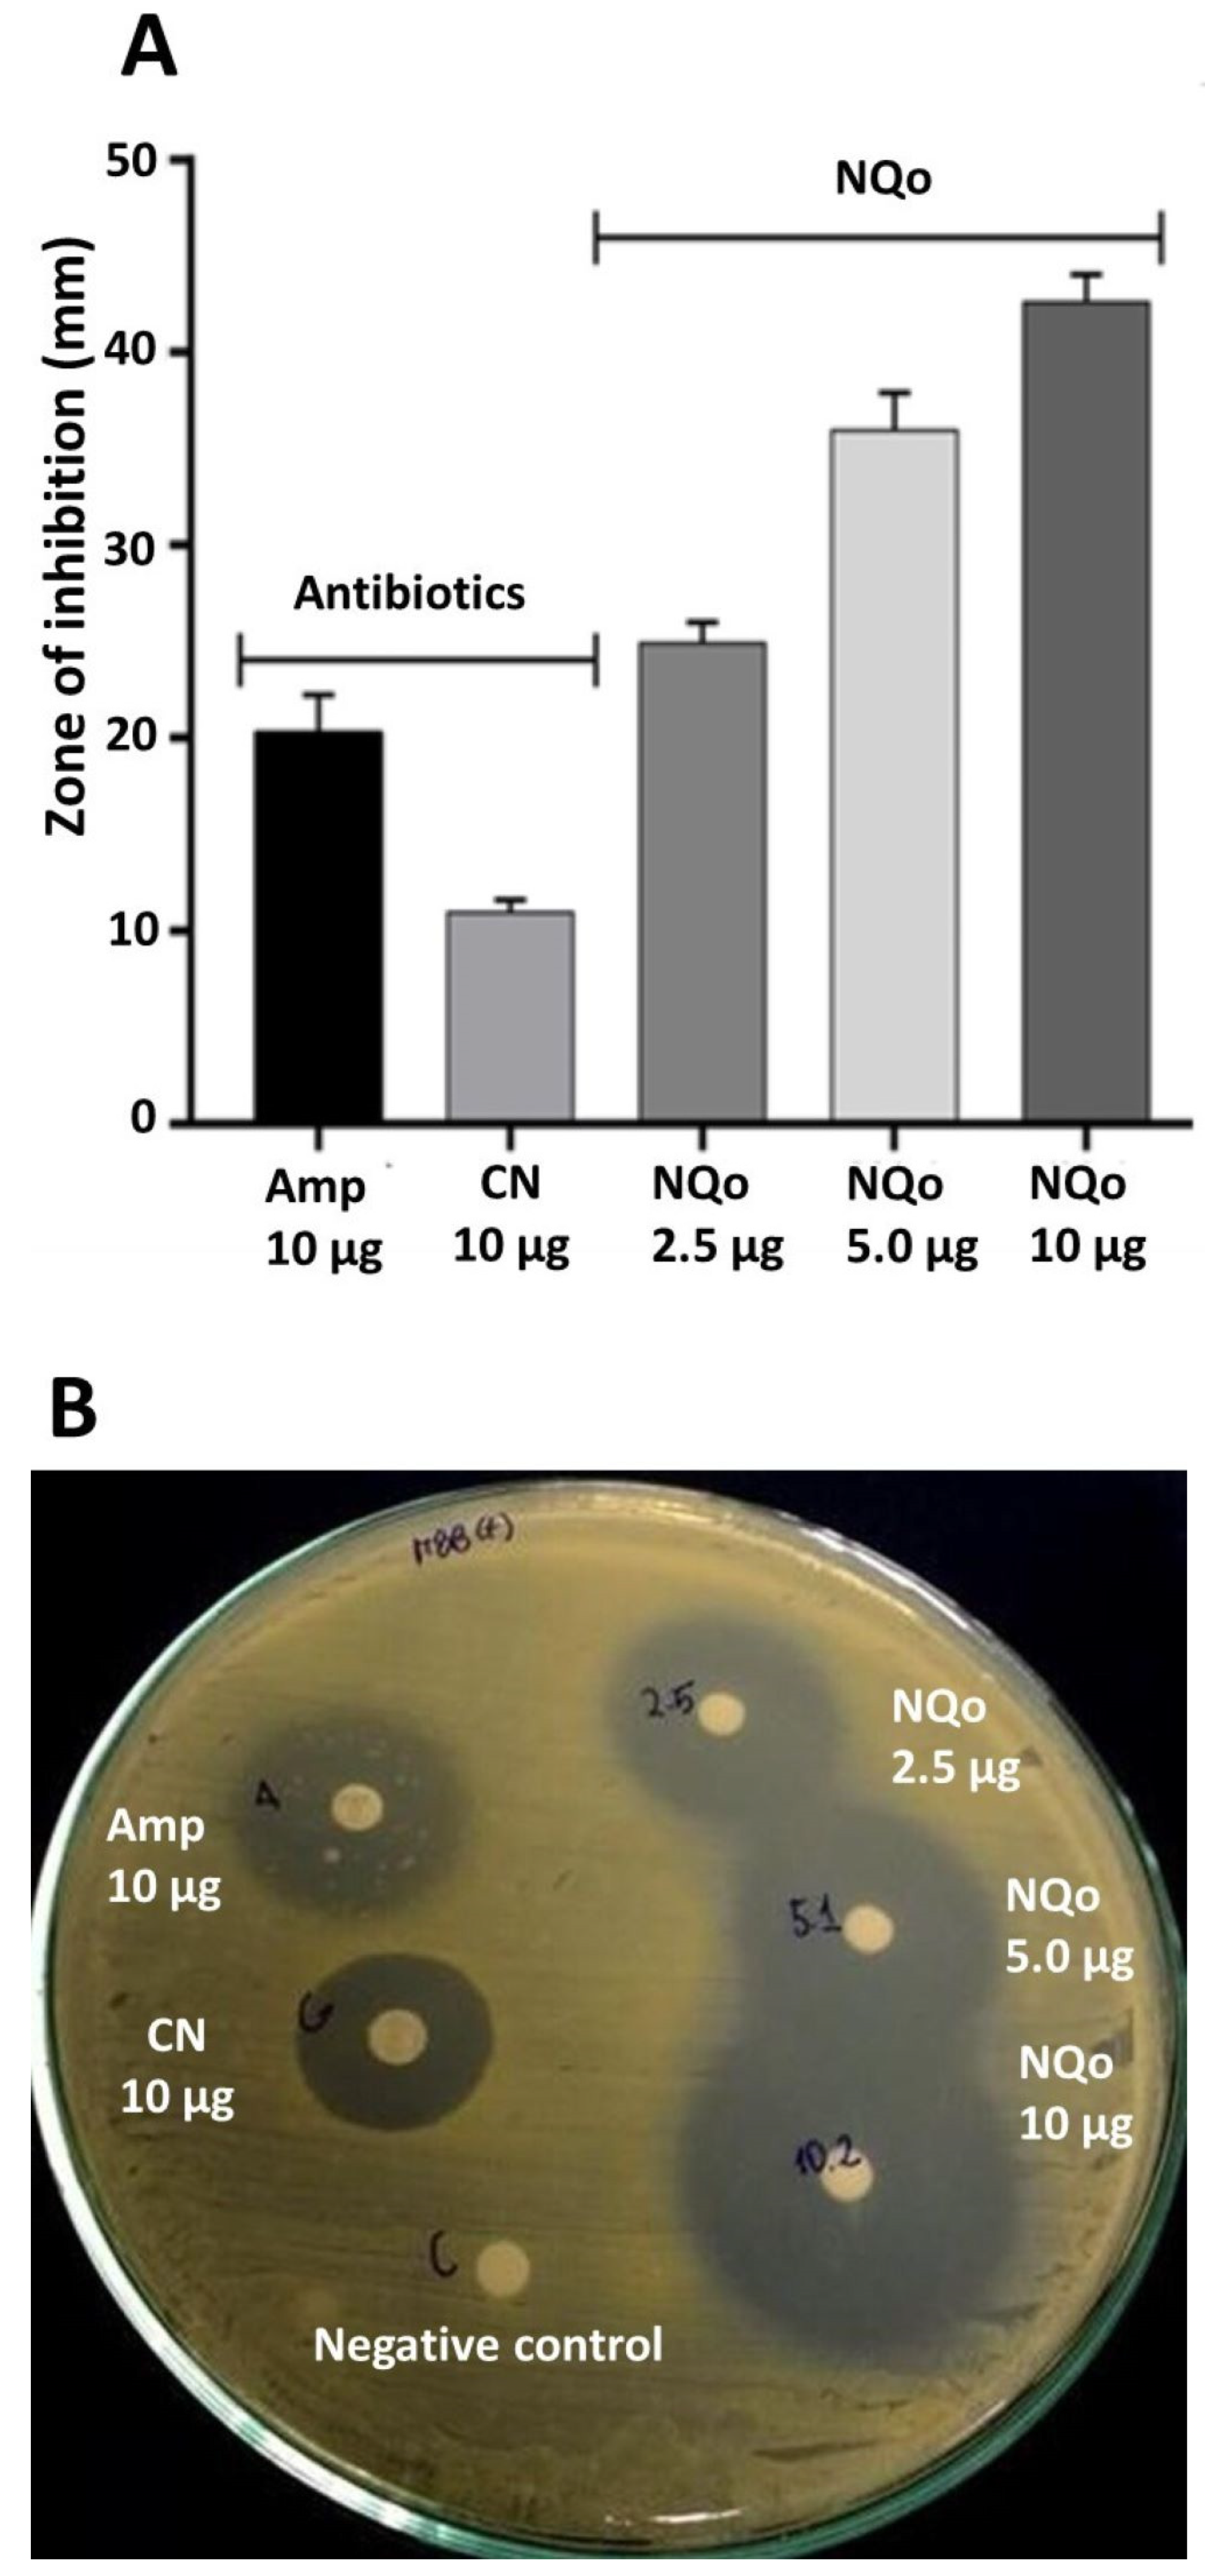
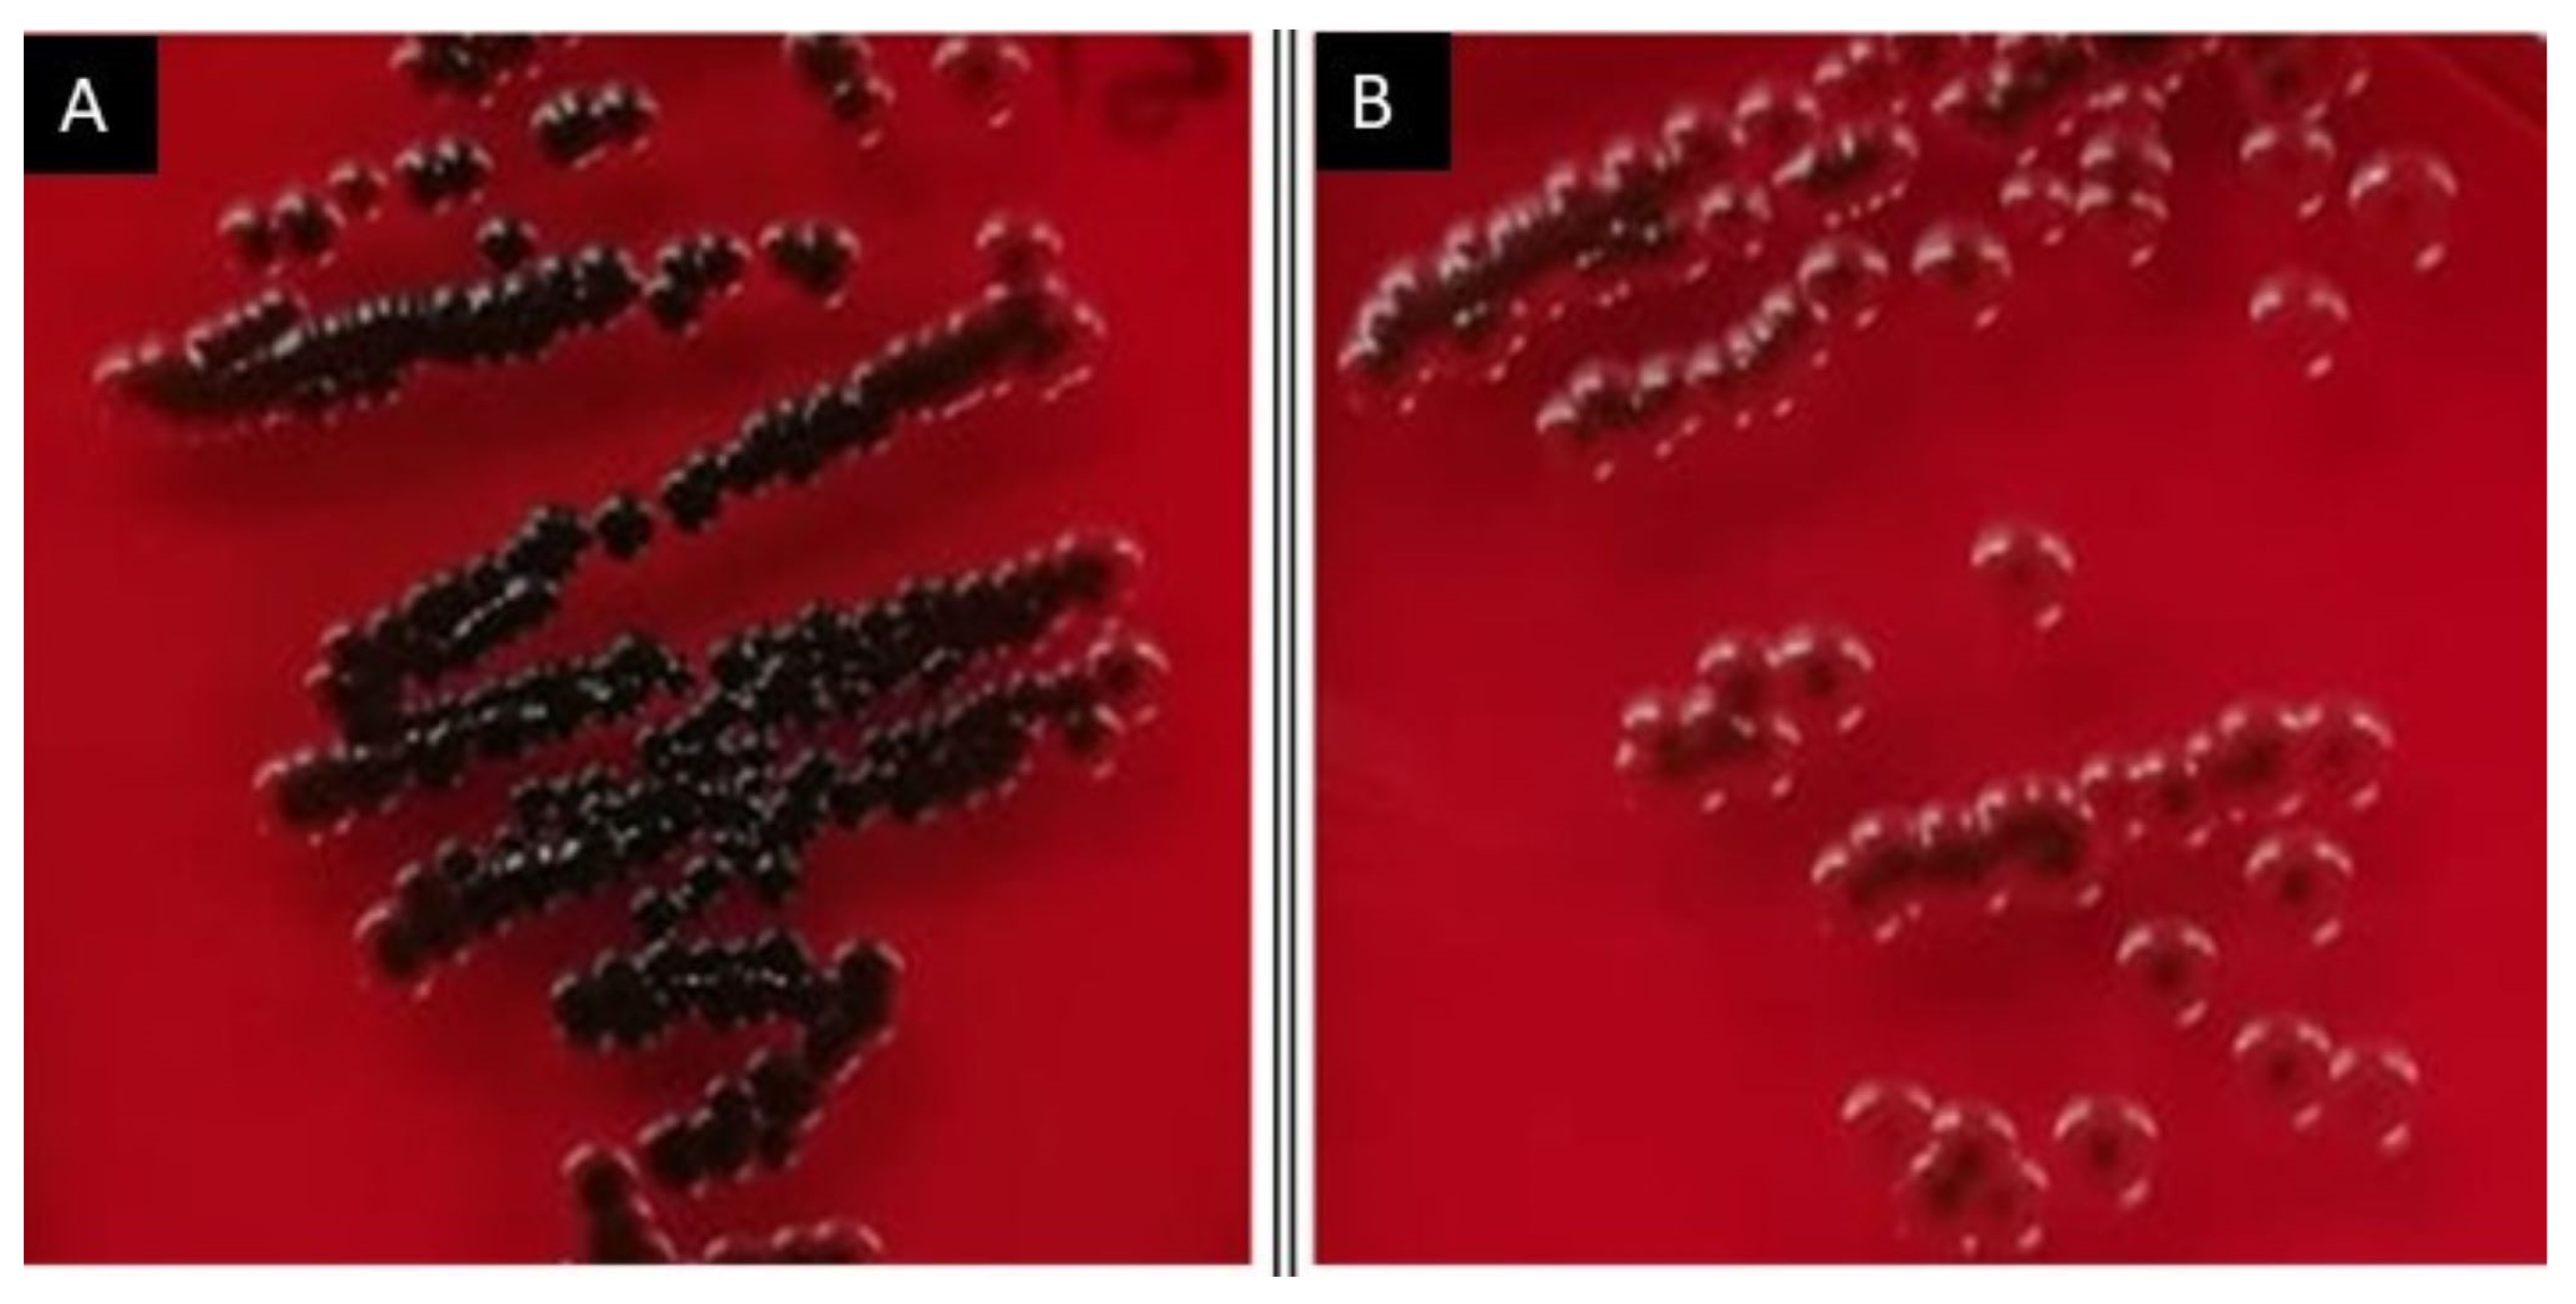

Antimicrobial and Antibiofilm Activity of Chitosan Nanoparticles Against Staphylococcus aureus Strains Isolated from Bovine Mastitis Milk
Abstract
1. Introduction
2. Materials and Methods
2.1. Materials
2.2. Synthesis of Chitosan Nanoparticles (NQo)
2.3. Characterization of NQo
2.3.1. Determination of Size, Zeta Potential, and Polydispersity Index
2.3.2. Transmission Electron Microscopy (TEM)
2.4. S. aureus Strains from Mastitis Bovine Milk Samples

2.5. Quantification of Biofilm Production Capacity Using Crystal Violet
- OD ≤ ODcut = Non-biofilm-former (NBF).
- ODcut < OD ≤ 2 × ODcut = Weak biofilm-former (WBF).
- 2 × ODcut < OD ≤ 4 × ODcut = Moderate biofilm-former (MBF).
- OD ˃ 4 × ODcut = Strong biofilm-former.
2.6. Congo Red Agar (CRA) Assay
2.7. Assays to Determination of the Minimum Inhibitory and Bactericidal Concentrations of NQo
2.8. Disk Diffusion Test: Performance of NQo Versus Conventional Antibiotics
2.9. Biofilm Inhibition by NQo
2.10. Statistical Analysis
3. Results
3.1. Characterization of Chitosan Nanoparticles (NQo)
3.2. Biochemical and Molecular Characterization of S. aureus from Milk Samples
3.3. Characterization of Biofilm Formation Capacity (BFC) Using S. aureus Isolated from Milk Samples of Cows Diagnosed with BM
3.4. Minimum Inhibitory Concentration and Minimum Bactericidal Concentration
3.5. Disk Diffusion Test and Comparison of NQo to Conventional Antibiotics
3.6. NQo Reduce Biofilm Formation of S. aureus
4. Discussion
4.1. Characterization of Chitosan Nanoparticles (NQo)
4.2. Antimicrobial Capacity of NQo
4.2.1. The Minimum Inhibitory Concentration (MIC) and the Minimum Bactericidal Concentration (MBC)
4.2.2. Disk Diffusion Test and Comparison of NQo to Conventional Antibiotics
4.2.3. NQo Reduce Biofilm Formation of S. aureus
5. Conclusions
Author Contributions
Funding
Institutional Review Board Statement
Informed Consent Statement
Data Availability Statement
Conflicts of Interest
References
- Morales-Ubaldo, A.L.; Rivero-Perez, N.; Valladares-Carranza, B.; Velázquez-Ordoñez, V.; Delgadillo-Ruiz, L.; Zaragoza-Bastida, A. Bovine Mastitis, a Worldwide Impact Disease: Prevalence, Antimicrobial Resistance, and Viable Alternative Approaches. Vet. Anim. Sci. 2023, 21, 100306. [Google Scholar] [CrossRef] [PubMed]
- Potential Biomarkers of Mastitis in Dairy Cattle Milk Identified. Available online: https://www.gla.ac.uk/schools/bohvm/about/news/newsfrom2016/headline_696560_en.html (accessed on 21 December 2024).
- Fessia, A.S.; Dieser, S.A.; Raspanti, C.G.; Odierno, L.M. Genotyping and Study of Adherence-Related Genes of Streptococcus Uberis Isolates from Bovine Mastitis. Microb. Pathog. 2019, 130, 295–301. [Google Scholar] [CrossRef] [PubMed]
- Angelopoulou, A.; Holohan, R.; Rea, M.C.; Warda, A.K.; Hill, C.; Ross, R.P. Bovine Mastitis Is a Polymicrobial Disease Requiring a Polydiagnostic Approach. Int. Dairy J. 2019, 99, 104539. [Google Scholar] [CrossRef]
- Aslantaş, Ö.; Demir, C. Investigation of the Antibiotic Resistance and Biofilm-Forming Ability of Staphylococcus Aureus from Subclinical Bovine Mastitis Cases. J. Dairy Sci. 2016, 99, 8607–8613. [Google Scholar] [CrossRef]
- Martins, S.A.M.; Martins, V.C.; Cardoso, F.A.; Germano, J.; Rodrigues, M.; Duarte, C.; Bexiga, R.; Cardoso, S.; Freitas, P.P. Biosensors for On-Farm Diagnosis of Mastitis. Front. Bioeng. Biotechnol. 2019, 7, 186. [Google Scholar] [CrossRef]
- Klaas, I.C.; Zadoks, R.N. An Update on Environmental Mastitis: Challenging Perceptions. Transbound. Emerg. Dis. 2018, 65 (Suppl. 1), 166–185. [Google Scholar] [CrossRef]
- Barlow, J. Mastitis Therapy and Antimicrobial Susceptibility: A Multispecies Review with a Focus on Antibiotic Treatment of Mastitis in Dairy Cattle. J. Mammary Gland Biol. Neoplasia 2011, 16, 383–407. [Google Scholar] [CrossRef]
- Ruegg, P.L. A 100-Year Review: Mastitis Detection, Management, and Prevention. J. Dairy Sci. 2017, 100, 10381–10397. [Google Scholar] [CrossRef]
- Rivera Aguayo, P.; Bruna Larenas, T.; Alarcón Godoy, C.; Cayupe Rivas, B.; González-Casanova, J.; Rojas-Gómez, D.; Caro Fuentes, N. Antimicrobial and Antibiofilm Capacity of Chitosan Nanoparticles against Wild Type Strain of Pseudomonas Sp. Isolated from Milk of Cows Diagnosed with Bovine Mastitis. Antibiotics 2020, 9, 551. [Google Scholar] [CrossRef]
- Araujo, V.; Gamboa, A.; Caro, N.; Abugoch, L.; Gotteland, M.; Valenzuela, F.; Merchant, H.A.; Basit, A.W.; Tapia, C. Release of Prednisolone and Inulin from a New Calcium-Alginate Chitosan-Coated Matrix System for Colonic Delivery. J. Pharm. Sci. 2013, 102, 2748–2759. [Google Scholar] [CrossRef]
- Danielsen, S.; Vårum, K.M.; Stokke, B.T. Structural Analysis of Chitosan Mediated DNA Condensation by AFM: Influence of Chitosan Molecular Parameters. Biomacromolecules 2004, 5, 928–936. [Google Scholar] [CrossRef] [PubMed]
- Calvo, P.; Remuñán-López, C.; Vila-Jato, J.L.; Alonso, M.J. Novel Hydrophilic Chitosan-Polyethylene Oxide Nanoparticles as Protein Carriers. J. Appl. Polym. Sci. 1997, 63, 125–132. [Google Scholar] [CrossRef]
- Gamboa, A.; Araujo, V.; Caro, N.; Gotteland, M.; Abugoch, L.; Tapia, C. Spray Freeze-Drying as an Alternative to the Ionic Gelation Method to Produce Chitosan and Alginate Nano-Particles Targeted to the Colon. J. Pharm. Sci. 2015, 104, 4373–4385. [Google Scholar] [CrossRef] [PubMed]
- Medina, E.; Caro, N.; Abugoch, L.; Gamboa, A.; Díaz-Dosque, M.; Tapia, C. Chitosan Thymol Nanoparticles Improve the Antimicrobial Effect and the Water Vapour Barrier of Chitosan-Quinoa Protein Films. J. Food Eng. 2019, 240, 191–198. [Google Scholar] [CrossRef]
- Kamal, M.; Youssef, I.M.; Khalil, H.A.; Ayoub, M.A.; Hashem, N.M. Multifunctional Role of Chitosan in Farm Animals: A Comprehensive Review. Ann. Anim. Sci. 2023, 23, 69–86. [Google Scholar] [CrossRef]
- Neculai-Valeanu, A.-S.; Ariton, A.-M.; Radu, C.; Porosnicu, I.; Sanduleanu, C.; Amariții, G. From Herd Health to Public Health: Digital Tools for Combating Antibiotic Resistance in Dairy Farms. Antibiotics 2024, 13, 634. [Google Scholar] [CrossRef]
- Cheng, W.N.; Han, S.G. Bovine Mastitis: Risk Factors, Therapeutic Strategies, and Alternative Treatments—A Review. Asian-Australas. J. Anim. Sci. 2020, 33, 1699–1713. [Google Scholar] [CrossRef]
- Chandrasekaran, M.; Kim, K.; Chun, S. Antibacterial Activity of Chitosan Nanoparticles: A Review. Processes 2020, 8, 1173. [Google Scholar] [CrossRef]
- Yilmaz Atay, H. Antibacterial Activity of Chitosan-Based Systems. In Functional Chitosan; Jana, S., Jana, S., Eds.; Springer: Singapore, 2019; pp. 457–489. ISBN 9789811502620. [Google Scholar]
- Caro, N.; Medina, E.; Díaz-Dosque, M.; López, L.; Abugoch, L.; Tapia, C. Novel Active Packaging Based on Films of Chitosan and Chitosan/Quinoa Protein Printed with Chitosan-Tripolyphosphate-Thymol Nanoparticles via Thermal Ink-Jet Printing. Food Hydrocoll. 2016, 52, 520–532. [Google Scholar] [CrossRef]
- Stetefeld, J.; McKenna, S.A.; Patel, T.R. Dynamic Light Scattering: A Practical Guide and Applications in Biomedical Sciences. Biophys. Rev. 2016, 8, 409–427. [Google Scholar] [CrossRef]
- Khan, F.; Manivasagan, P.; Lee, J.-W.; Pham, D.T.N.; Oh, J.; Kim, Y.-M. Fucoidan-Stabilized Gold Nanoparticle-Mediated Biofilm Inhibition, Attenuation of Virulence and Motility Properties in Pseudomonas Aeruginosa PAO1. Mar. Drugs 2019, 17, 208. [Google Scholar] [CrossRef] [PubMed]
- Kaiser, T.D.L.; Pereira, E.M.; dos Santos, K.R.N.; Maciel, E.L.N.; Schuenck, R.P.; Nunes, A.P.F. Modification of the Congo Red Agar Method to Detect Biofilm Production by Staphylococcus epidermidis. Diagn. Microbiol. Infect. Dis. 2013, 75, 235–239. [Google Scholar] [CrossRef] [PubMed]
- Han, C.; Goodwine, J.; Romero, N.; Steck, K.S.; Sauer, K.; Doiron, A. Enzyme-Encapsulating Polymeric Nanoparticles: A Potential Adjunctive Therapy in Pseudomonas Aeruginosa Biofilm-Associated Infection Treatment. Colloids Surf. B Biointerfaces 2019, 184, 110512. [Google Scholar] [CrossRef] [PubMed]
- Valero-Leal, K.; Valbuena, E.; Chacón, F.; Olivares, Y.; Castro, G.; Briñez, W. Patógenos contagiosos y ambientales aislados de cuartos mamarios con mastitis subclínica de alto riesgo en tres fincas del estado Zulia. Rev. Científica 2010, 20, 498–505. [Google Scholar]
- Ramalho, R.; Cunha, J.; Teixeira, P.; Gibbs, P.A. Modified Pseudomonas Agar: New Differential Medium for the Detection/Enumeration of Pseudomonas Aeruginosa in Mineral Water. J. Microbiol. Methods 2002, 49, 69–74. [Google Scholar] [CrossRef]
- Hudzicki, J. Kirby-Bauer-Disk Diffusion Susceptibility Test Protocol; The American Society for Microbiology: Washington, DC, USA, 2009. [Google Scholar]
- Ball, A.L.; Augenstein, E.D.; Wienclaw, T.M.; Richmond, B.C.; Freestone, C.A.; Lewis, J.M.; Thompson, J.S.; Pickett, B.E.; Berges, B.K. Characterization of Staphylococcus Aureus Biofilms via Crystal Violet Binding and Biochemical Composition Assays of Isolates from Hospitals, Raw Meat, and Biofilm-Associated Gene Mutants. Microb. Pathog. 2022, 167, 105554. [Google Scholar] [CrossRef]
- Yue, Y.; Kan, Y.; Choi, H.; Clearfield, A.; Liang, H. Correlating Hydrodynamic Radii with That of Two-Dimensional Nanoparticles. Appl. Phys. Lett. 2015, 107, 253103. [Google Scholar] [CrossRef]
- Bhattarai, S.; Perumal, D.; Rathbone, M.J.; Bunt, C.R.; Alany, R.G. On the Biocompatibility and Teat Retention of In Situ Gelling Intramammary Formulations: Cattle Mastitis Prevention and Treatment. Pharmaceutics 2021, 13, 1732. [Google Scholar] [CrossRef]
- Wilm, J.; Svennesen, L.; Kirkeby, C.; Krömker, V. Treatment of Clinically Severe Bovine Mastitis—A Scoping Review. Front. Vet. Sci. 2024, 11, 1286461. [Google Scholar] [CrossRef]
- Elmehbad, N.Y.; Mohamed, N.A.; Abd El-Ghany, N.A. Evaluation of the Antimicrobial and Anti-Biofilm Activity of Novel Salicylhydrazido Chitosan Derivatives Impregnated with Titanium Dioxide Nanoparticles. Int. J. Biol. Macromol. 2022, 205, 719–730. [Google Scholar] [CrossRef]
- Vimal, A.; Kumar, A. Antimicrobial Potency Evaluation of Free and Immobilized L-Asparaginase Using Chitosan Nanoparticles. J. Drug Deliv. Sci. Technol. 2021, 61, 102231. [Google Scholar] [CrossRef]
- Orellano, M.S.; Isaac, P.; Breser, M.L.; Bohl, L.P.; Conesa, A.; Falcone, R.D.; Porporatto, C. Chitosan Nanoparticles Enhance the Antibacterial Activity of the Native Polymer against Bovine Mastitis Pathogens. Carbohydr. Polym. 2019, 213, 1–9. [Google Scholar] [CrossRef] [PubMed]
- Felipe, V.; Breser, M.L.; Bohl, L.P.; Rodrigues Da Silva, E.; Morgante, C.A.; Correa, S.G.; Porporatto, C. Chitosan Disrupts Biofilm Formation and Promotes Biofilm Eradication in Staphylococcus Species Isolated from Bovine Mastitis. Int. J. Biol. Macromol. 2019, 126, 60–67. [Google Scholar] [CrossRef]
- Kucharska, M.; Sikora, M.; Brzoza-Malczewska, K.; Owczarek, M. Antimicrobial Properties of Chitin and Chitosan. In Chitin and Chitosan; Broek, L.A.M., Boeriu, C.G., Eds.; Wiley: Hoboken, NJ, USA, 2019; pp. 169–187. ISBN 978-1-119-45043-6. [Google Scholar]
- Banu, M.G.; Zewdu Geberemedhin, E. Occurrence and Antimicrobial Susceptibility of Staphylococcus Aureus in Dairy Farms and Personnel in Selected Towns of West Shewa Zone, Oromia, Ethiopia. PLoS ONE 2022, 17, e0277805. [Google Scholar] [CrossRef]
- Szczuka, E.; Porada, K.; Wesołowska, M.; Łęska, B. Occurrence and Characteristics of Staphylococcus Aureus Isolated from Dairy Products. Molecules 2022, 27, 4649. [Google Scholar] [CrossRef]
- Saeed, S.I.; Mat Yazid, K.A.; Hashimy, H.A.; Dzulkifli, S.K.; Nordin, F.; Nik Him, N.A.; Omar, M.F.F.B.; Aklilu, E.; Mohamad, M.; Zalati, C.W.S.; et al. Prevalence, Antimicrobial Resistance, and Characterization of Staphylococcus Aureus Isolated from Subclinical Bovine Mastitis in East Coast Malaysia. Animals 2022, 12, 1680. [Google Scholar] [CrossRef]
- Shi, S.; Jia, J.; Guo, X.; Zhao, Y.; Chen, D.; Guo, Y.; Zhang, X. Reduced Staphylococcus Aureus Biofilm Formation in the Presence of Chitosan-Coated Iron Oxide Nanoparticles. Int. J. Nanomed. 2016, 11, 6499–6506. [Google Scholar] [CrossRef]
- Siddhardha, B.; Pandey, U.; Kaviyarasu, K.; Pala, R.; Syed, A.; Bahkali, A.; Elgorban, A. Chrysin-Loaded Chitosan Nanoparticles Potentiates Antibiofilm Activity against Staphylococcus Aureus. Pathogens 2020, 9, 115. [Google Scholar] [CrossRef]
- Orellano, M.S.; Bohl, L.P.; Breser, M.L.; Isaac, P.; Falcone, R.D.; Porporatto, C. A Comparative Study of Antimicrobial Activity of Differently-Synthesized Chitosan Nanoparticles against Bovine Mastitis Pathogens. Soft Matter 2021, 17, 694–703. [Google Scholar] [CrossRef]
- Tan, Y.; Ma, S.; Leonhard, M.; Moser, D.; Haselmann, G.M.; Wang, J.; Eder, D.; Schneider-Stickler, B. Enhancing Antibiofilm Activity with Functional Chitosan Nanoparticles Targeting Biofilm Cells and Biofilm Matrix. Carbohydr. Polym. 2018, 200, 35–42. [Google Scholar] [CrossRef]
- Hemmati, F.; Salehi, R.; Ghotaslou, R.; Kafil, H.S.; Hasani, A.; Gholizadeh, P.; Rezaee, M.A. The Assessment of Antibiofilm Activity of Chitosan-Zinc Oxide-Gentamicin Nanocomposite on Pseudomonas Aeruginosa and Staphylococcus Aureus. Int. J. Biol. Macromol. 2020, 163, 2248–2258. [Google Scholar] [CrossRef] [PubMed]
- Khan, F.; Lee, J.-W.; Manivasagan, P.; Pham, D.T.N.; Oh, J.; Kim, Y.-M. Synthesis and Characterization of Chitosan Oligosaccharide-Capped Gold Nanoparticles as an Effective Antibiofilm Drug against the Pseudomonas Aeruginosa PAO1. Microb. Pathog. 2019, 135, 103623. [Google Scholar] [CrossRef] [PubMed]
- Wang, Z.; Bai, H.; Lu, C.; Hou, C.; Qiu, Y.; Zhang, P.; Duan, J.; Mu, H. Light Controllable Chitosan Micelles with ROS Generation and Essential Oil Release for the Treatment of Bacterial Biofilm. Carbohydr. Polym. 2019, 205, 533–539. [Google Scholar] [CrossRef] [PubMed]
- Paluch, E.; Rewak-Soroczyńska, J.; Jędrusik, I.; Mazurkiewicz, E.; Jermakow, K. Prevention of Biofilm Formation by Quorum Quenching. Appl. Microbiol. Biotechnol. 2020, 104, 1871–1881. [Google Scholar] [CrossRef]

| Sample | Z-Average (nm) | PDI | Zeta Potential (ζ) (mV) |
|---|---|---|---|
| NQo-1 | 122.2 | 0.678 | +52.6 |
| NQo-2 | 120.0 | 0.666 | +56.3 |
| NQo-3 | 117.1 | 0.661 | +57.3 |
| Average | 119.8 ± 2.6 | 0.668 ± 0.009 | +55.4 ± 2.5 |
| Strain of S. aureus Sample Identification | Biofilm Quantification (OD CV Assay) | Biofilm Formation Capacity (ODcut Method) | Phenotype CRA |
|---|---|---|---|
| M10 | 0.325 ± 0.03 | Strong | Positive |
| M11 | 0.293 ± 0.05 | Intermediate | Positive |
| M12 | 0.298 ± 0.02 | Intermediate | Positive |
| M13 | 0.213 ± 0.03 | Intermediate | Negative |
| M14 | 0.164 ± 0.05 | Weak | Negative |
| M15 | 0.317 ± 0.02 | Strong | Positive |
| Strains | MIC (μg/mL) | MBC (μg/mL) | MIC/MBC |
|---|---|---|---|
| M10 | 128 | 250 | 1.95 |
| M11 | 128 | 250 | 1.95 |
| M12 | 128 | 250 | 1.95 |
| M13 | 128 | 250 | 1.95 |
| M14 | 128 | 250 | 1.95 |
| M15 | 128 | 250 | 1.95 |
| Zone of Inhibition (mm) | ||
|---|---|---|
| S. aureus strain | Amp | CN |
| M10 | 22.18 ± 1.34 | 12.32 ± 0.78 |
| M11 | 23.85 ± 1.66 | 14.79 ± 0.98 |
| M12 | 22.45 ± 2.02 | 13.12 ± 0.65 |
| M13 | 21.29 ± 1.45 | 12.67 ± 0.34 |
| M14 | 22.18 ± 1.22 | 13.88 ± 0.63 |
| M15 | 20.35 ± 1.88 | 11.04 ± 0.56 |
Disclaimer/Publisher’s Note: The statements, opinions and data contained in all publications are solely those of the individual author(s) and contributor(s) and not of MDPI and/or the editor(s). MDPI and/or the editor(s) disclaim responsibility for any injury to people or property resulting from any ideas, methods, instructions or products referred to in the content. |
© 2025 by the authors. Licensee MDPI, Basel, Switzerland. This article is an open access article distributed under the terms and conditions of the Creative Commons Attribution (CC BY) license (https://creativecommons.org/licenses/by/4.0/).
Share and Cite
Godoy, C.A.; Balic, I.; Moreno, A.A.; Diaz, O.; Arenas Colarte, C.; Bruna Larenas, T.; Gamboa, A.; Caro Fuentes, N. Antimicrobial and Antibiofilm Activity of Chitosan Nanoparticles Against Staphylococcus aureus Strains Isolated from Bovine Mastitis Milk. Pharmaceutics 2025, 17, 186. https://doi.org/10.3390/pharmaceutics17020186
Godoy CA, Balic I, Moreno AA, Diaz O, Arenas Colarte C, Bruna Larenas T, Gamboa A, Caro Fuentes N. Antimicrobial and Antibiofilm Activity of Chitosan Nanoparticles Against Staphylococcus aureus Strains Isolated from Bovine Mastitis Milk. Pharmaceutics. 2025; 17(2):186. https://doi.org/10.3390/pharmaceutics17020186
Chicago/Turabian StyleGodoy, Carlos Alarcón, Iván Balic, Adrián A. Moreno, Oscar Diaz, Carla Arenas Colarte, Tamara Bruna Larenas, Alexander Gamboa, and Nelson Caro Fuentes. 2025. "Antimicrobial and Antibiofilm Activity of Chitosan Nanoparticles Against Staphylococcus aureus Strains Isolated from Bovine Mastitis Milk" Pharmaceutics 17, no. 2: 186. https://doi.org/10.3390/pharmaceutics17020186
APA StyleGodoy, C. A., Balic, I., Moreno, A. A., Diaz, O., Arenas Colarte, C., Bruna Larenas, T., Gamboa, A., & Caro Fuentes, N. (2025). Antimicrobial and Antibiofilm Activity of Chitosan Nanoparticles Against Staphylococcus aureus Strains Isolated from Bovine Mastitis Milk. Pharmaceutics, 17(2), 186. https://doi.org/10.3390/pharmaceutics17020186

